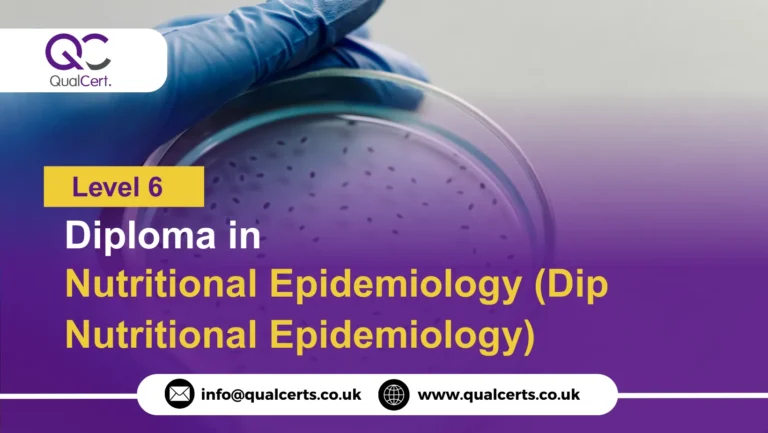
QualCert Level 6 Diploma in Nutritional Epidemiology (Dip Nutritional Epidemiology)

In today’s world, where lifestyle-related diseases are on the rise, the importance of healthy eating and proper nutrition has never been greater. People are becoming more conscious about what they eat — and that’s where Nutrition and Dietetics professionals play a crucial role.
Nutrition and Dietetics courses prepare learners to understand how food affects health, prevent diseases through diet, and guide people toward balanced lifestyles. It’s a perfect blend of science, health, and care — ideal for those passionate about wellness and helping others live healthier lives.
Nutrition and Dietetics is the science of food, nutrients, and their relationship with human health. These courses train students to assess dietary needs, plan nutrition programs, and develop meal plans for individuals or communities.
By studying Nutrition and Dietetics, you gain the expertise to help people eat smarter, prevent diseases, and lead healthier, happier lives. Whether your goal is to work in a hospital, start your own clinic, or influence public health policy — this field offers endless opportunities to nourish the world through knowledge.